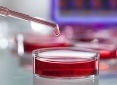

Dr. Kirchhoff
Wilhelmstraße 9
35781 Weilburg/Lahn
Tel: 06471-93720
Fax: 06471/937220
info@kirchhoff-anwalt.de
Notfallnummer: 0171/6252091
Wilhelmstraße 9
35781 Weilburg/Lahn
Tel: 06471-
info@kirchhoff-
Notfallnummer: 0171/6252091
Weitere Webseiten unserer Kanzlei:
Kanzlei Kirchhoff
Krankenhausinfektionen/Sepsis
Zähne / Kieferorthopädie
Kanzlei Kirchhoff
Krankenhausinfektionen/Sepsis
Zähne / Kieferorthopädie






Bericht der WNZ
"Hygienefehler sind doch Alltag"
"Hygienefehler sind doch Alltag"

Ebola-Pandemie in Deutschland nach
Expertenansicht ausschließbar -


"Deutschlands beste Kliniken"
- Focus Heft Nr. 39
-
Kritische Anmerkungen
von Dr. Burkhard
Kirchhoff zum aktuellen
Focus Aufmacher
vom 22.9.2014
finden sie hier
von Dr. Burkhard
Kirchhoff zum aktuellen
Focus Aufmacher
vom 22.9.2014
finden sie hier

"Hart aber Fair: Faktencheck
Den Faktencheck zur
Sendung vom 02.06.2014
"Wie krank sind unsere
Krankenhäuser ?"
finden sie hier:
Video
Sendung vom 02.06.2014
"Wie krank sind unsere
Krankenhäuser ?"
finden sie hier:
Video


hr-iNFO Fit & Gesund
Die Sendung für Körper und Seele
Was tun gegen Antibiotika-Resistenzen?
Was tun gegen Antibiotika-


MRSA▪Infektion von Klinikpersonal
als Berufskrankheit anerkannt!
als Berufskrankheit anerkannt!


Das neue Qualitätsgesetz
von Gesundheitsminister Gröhe
von Gesundheitsminister Gröhe


Inkompetente und fachfremde
Gutachter vor Gericht?
Gutachter vor Gericht?

"Hände weg von Keimen"

Printmedien und Hörfunk
berichten über unsere
Kampagne
"No Handshake".
Einen ersten Artikel
der WNZ vom 9.5.2014
finden sie hier.
berichten über unsere
Kampagne
"No Handshake".
Einen ersten Artikel
der WNZ vom 9.5.2014
finden sie hier.

Patientenkanzlei Dr. Kirchhoff
Mitglied im Netzwerk zur
Bekämpfung multi-
Mehr Informationen
Mitglied im Netzwerk zur
Bekämpfung multi-
Mehr Informationen


"Völlig überzogen" oder "zu niedrige
Zahlen von Behandlungsfehlern"

Der an Rechtsverweigerung grenzende
Umgang einzelner Gerichte
mit den Rechten geschädigter
Patienten in Kunstfehler-
medizinischen Makroproblem
der Krankenhausinfektionen.
Anmerkungen finden sie hier
Patienten in Kunstfehler-
medizinischen Makroproblem
der Krankenhausinfektionen.
Anmerkungen finden sie hier


Infektionen in Deutschland
und das System der Fallpauschalen
und das System der Fallpauschalen

Manipulierte Infektionszahlen
in Deutschland?
in Deutschland?
Anmerkungen zu den
fragwürdigen "offiziellen
Infektionszahlen" sowie
den Zahlen der Letalität.
Hohe Präventionspotentiale
nosokomialer Infektionen
in Deutschland.
fragwürdigen "offiziellen
Infektionszahlen" sowie
den Zahlen der Letalität.
Hohe Präventionspotentiale
nosokomialer Infektionen
in Deutschland.


Fragen zu Zahlen und Entwicklungen
bei nosokomialen Infektionen an
das Robert Koch Institut
bei nosokomialen Infektionen an
das Robert Koch Institut


Keine flächendeckend
lückenlose Klinikkontrolle -
lückenlose Klinikkontrolle -


Richtungsstreit der deutschen
Krankenhaushygiene?
Krankenhaushygiene?


Wieder ein wichtiges Urteil
für MRSA- und Sepsis-Opfer
für MRSA-


Das neue Infektionsschutzgesetz
Hat sich die Situation ver-
"Initiative Infektionsschutz"
Aktuelle Entwicklungen und
Forderungen zur Kranken-
finden Sie hier.
"Initiative Infektionsschutz"
Aktuelle Entwicklungen und
Forderungen zur Kranken-
finden Sie hier.


Umfrage "Initiative Infektionsschutz"
bei deutschen Krankenhäusern
bei deutschen Krankenhäusern
Ein offener Brief von
Patientenanwalt
Dr. Kirchhoff und
kritische Anmerkungen
zu dieser Umfrage
finden Sie hier.
Patientenanwalt
Dr. Kirchhoff und
kritische Anmerkungen
zu dieser Umfrage
finden Sie hier.


Unnötige Operationen in Deutschland -
Operationen als Umsatzfaktor
Am 13.2.2013 berichtete
das „ZDF- Volle Kanne“.
Den Fernsehbericht mit
Stellungnahmen
finden sie hier.
das „ZDF-
Den Fernsehbericht mit
Stellungnahmen
finden sie hier.


Ein "Lehrstück" für kaufmännische und
medizinische Klinikleiter in Deutschland
medizinische Klinikleiter in Deutschland

"Klebsiellen Oxa 48" Aus-
28 Todesfälle von
Patienten untersucht!
28 Todesfälle von
Patienten untersucht!

rbb Praxis
Tödliche Keime
im Krankenhaus
Tödliche Keime
im Krankenhaus
14.11.2012 20:15 Uhr - Mit Dr. Burkhard
Kirchhoff (Patientenanwalt) und Dr. Klaus
Dieter Zastrow (DGKH) - Video
Dieter Zastrow (DGKH) -


Tod in der Klinik ▪ Gefahr durch Keime
Talkrunde aus dem Haupt-
ZDF Kanal "Phoenix"
vom 30.10.2012.
Link zur Sendung
ZDF Kanal "Phoenix"
vom 30.10.2012.
Link zur Sendung


Sparen bei den Reinigungskräften -
Hygienemängel gefährden Patienten
"Kontraste" berichtet am
04.10.2012 über einen
von unserer Kanzlei ver-
Stellungnahme von
Patientenanwalt
Dr. Burkhard Kirchhoff.
04.10.2012 über einen
von unserer Kanzlei ver-
Stellungnahme von
Patientenanwalt
Dr. Burkhard Kirchhoff.


Exakt ▪ Die Story
"Tödliche Keime im
Krankenhaus" - mit
Stellungnahmen von
Patientenanwalt
Dr. Burkhard Kirchhoff,
Dr. Klaus-Dieter Zastrow.
Video...
Krankenhaus" -
Patientenanwalt
Dr. Burkhard Kirchhoff,
Dr. Klaus-


Mehr Tote durch Ärztepfusch?
Nur eine „reißerische“ Meldung?
Nur eine „reißerische“ Meldung?


Schadensersatzforderungen
wegen fehlerhafter Medizinprodukte
wegen fehlerhafter Medizinprodukte

„Billig-Brustimplantate, Hüften,
Knieprothesen und Stents“ –
Wer muss zahlen ?
Eine Stellungnahme von
Patientenanwalt Dr. Burkhard
Kirchhoff finden sie hier.
Wer muss zahlen ?
Eine Stellungnahme von
Patientenanwalt Dr. Burkhard
Kirchhoff finden sie hier.

Ausbruchsmanagement in
Deutschland und der Fall Leipzig
Deutschland und der Fall Leipzig

Anmerkungen von
Patientenanwalt Dr.
Kirchhoff zum "Leipziger
KPC Ausbruch" und zum
Ausbruchsmanagement
in Deutschland
Patientenanwalt Dr.
Kirchhoff zum "Leipziger
KPC Ausbruch" und zum
Ausbruchsmanagement
in Deutschland

"Zahlenspiele" der Deutschen
Gesellschaft für Krankenhaushygiene?
Gesellschaft für Krankenhaushygiene?

Stark schwankende Fall-
Krankenhausinfektionen
in Deutschland?
Wir haben Fragen
und fordern Antworten!
Krankenhausinfektionen
in Deutschland?
Wir haben Fragen
und fordern Antworten!

ARD beckmann ▪ Krankenhauskeime
- die unsichtbare Gefahr
-


Gefahr durch Krankenhauskeime
Fernsehmagazin M€X 12.10.2011
Fernsehmagazin M€X 12.10.2011
Prof. Dr. Alexander Friedrich, Patientenanwalt
Dr. Burkhard Kirchhoff und ein vertretener
Patient kamen zu Wort. Das Video hier:
Dr. Burkhard Kirchhoff und ein vertretener
Patient kamen zu Wort. Das Video hier:

"Markt" ▪ WDR Fernsehen 25.07.2011
Zu Wort kamen in dem Fernsehbeitrag
Professor Dr. Alexander Friedrich, Dr. Klaus-
Dr. Burkhard Kirchhoff.
Die Sendung in Textform finden sie hier:
Professor Dr. Alexander Friedrich, Dr. Klaus-
Dr. Burkhard Kirchhoff.
Die Sendung in Textform finden sie hier:

Krank durch Klinikkeime –
Die unterschätzte Gefahr 31.10.2010
Die unterschätzte Gefahr 31.10.2010
Nina Ruge diskutiert mit:
Dr. Alexander Friedrich,
Dr. Burkhard Kirchhoff,
Dr. Rudolf Kösterst und
Prof. Dr. Martin Mielke.
Informationen
Dr. Alexander Friedrich,
Dr. Burkhard Kirchhoff,
Dr. Rudolf Kösterst und
Prof. Dr. Martin Mielke.
Informationen


Antibiotikaforschung in
staatlicher Hand?
staatlicher Hand?
Ist Deutschland und die
Welt gegen „super-bugs“
gewappnet? Kritische
Anmerkungen zur Situation
von Patientenanwalt
Dr. Kirchhoff.
Welt gegen „super-
Anmerkungen zur Situation
von Patientenanwalt
Dr. Kirchhoff.


Kanzlei Dr. Kirchhoff erwirkt Grund-
Patienten

Nicht alle Ärzte halten dem Druck stand

Krankenhausinfektion,
hoher Risikofaktor für Patienten
hoher Risikofaktor für Patienten


Kunstfehler in Deutschland
Was ist das Leben eines Patienten wert ?
Den Bericht der WNZ vom 17.10.2014 über
einen Fall unserer Kanzlei finden sie hier
Den Bericht der WNZ vom 17.10.2014 über
einen Fall unserer Kanzlei finden sie hier

Das Interview mit Patientenanwalt
Dr. Kirchhoff zur Infektions-Prävention
in Deutschland
Dr. Kirchhoff zur Infektions-
aus der WNZ vom 9.10.2014 finden sie hier
Streit um den "AOK-Report" zu Behandlungs-
fehlern in Deutschland - WNZ Artikel vom
30.01.2014 mit Diskussionsbeiträgen des
Hess. Klinikverbundes und Dr. Kirchhoff.
Hess. Klinikverbundes und Dr. Kirchhoff.

Keimausbruch in Kiel ▪ Viele Fragen
Und bisher wenig „Antworten“!
Und bisher wenig „Antworten“!
Effektives Ausbruchsmanage-
Unser Kommentar und
konkrete Fragen zum Fall
Kiel finden Sie hier
Unser Kommentar und
konkrete Fragen zum Fall
Kiel finden Sie hier


Ein Meilenstein für Infektionsopfer
Neues Urteil des Oberlandes-
Signalwirkung für Sepsis-
Mehr erfahren sie hier
Signalwirkung für Sepsis-
Mehr erfahren sie hier


MRSA Screening und
Patientensicherheit in Deutschland?
Patientensicherheit in Deutschland?
Zweifelhaftes Positionspapier
des Aktionsbündnisses
„Patientensicherheit"
Einen kritischen Kommentar
von Patientenanwalt
Dr. Kirchhoff finden sie hier.
des Aktionsbündnisses
„Patientensicherheit"
Einen kritischen Kommentar
von Patientenanwalt
Dr. Kirchhoff finden sie hier.


Keime auf Kinderintensivstation
in Düsseldorf
in Düsseldorf



Pressekonferenz in Kiel ▪ 31 betroffene
Menschen davon 12 Tote ▪ viele Fragen:
Menschen davon 12 Tote ▪ viele Fragen:
Schicksal? - Wir dachten,
wir hätten es "im Griff"
Einen Kommentar von
Patientenanwalt Dr.
Kirchhoff finden sie hier
Einen Kommentar von
Patientenanwalt Dr.
Kirchhoff finden sie hier

Hygieneskandal Mannheim
Rücktrittsforderung gegen
Aufsichtsrat
Den Artikel der WAZ mit einer
Stellungnahme u.a. von
Patientenanwalt Dr. Kirchhoff
finden sie hier
Aufsichtsrat
Den Artikel der WAZ mit einer
Stellungnahme u.a. von
Patientenanwalt Dr. Kirchhoff
finden sie hier


Hygiene Skandal Mannheim



„Wert“ des Lebens vor Gerichten:
Null Schmerzensgeld bei Tod des Patienten
Null Schmerzensgeld bei Tod des Patienten

Antibiotika erst nach
Antibiogramm!
Antibiogramm!


Wichtiges „Universal-Screening MRSA“


Killerbrut -
Die verschwiegene Katastrophe

Krankenhausinfektionen in Deutschland


Krankenhausinfektionen


„Notfall“ deutscher Journalismus?


ARD Magazin Kontraste 28.11.2014
Tödliche Keime im Krankenhaus
Tödliche Keime im Krankenhaus
In der Sendung wurde ein
von uns vertretenes Fall-
Die Politik ist dringend
gefordert.
von uns vertretenes Fall-
Die Politik ist dringend
gefordert.


Für die Patienten kämpfen -
Fehlbehandlungen sind heute
keine Seltenheit. Oft ist
anwaltliche Hilfe vonnöten.
Den Artikel finden Sie hier
keine Seltenheit. Oft ist
anwaltliche Hilfe vonnöten.
Den Artikel finden Sie hier

Medizinskandal mit potentiell
dramatischen Folgen für Patienten
dramatischen Folgen für Patienten


Krankenhauskeime ▪ Könnes kämpft!
Reportage im WDR vom 01.12.2014


Krankenhauskeime ▪ Haben wir kapituliert?

Montag 12.01.2015 um 20.15 im BR3

Hart aber Fair ▪ Montag 2. Juni 2014
Profit vor Patient - wie krank
sind unsere Krankenhäuser?
Profit vor Patient -


Sat1 „akte Thema“ mit Ullrich Meyer
12.01.2012 „Achtung Killerkeime – So blei-
Burkhard Kirchhoff im Interview –
Burkhard Kirchhoff im Interview –


Patientenleid durch Keime

Mitschuld der
deutschen Politik und
Teilen der Justiz
deutschen Politik und
Teilen der Justiz

Schmerzensgeld und Menschenwürde



Krankenhausinfektionen in Europa
Neue ECDC Studie
Neue ECDC Studie

Deutlich zu niedrige
Infektionszahlen?
Infektionszahlen?

WDR 5 Stadtgespräch
Klinikkeime in
Deutschland ▪
Das Versagen
der Politik
Deutschland ▪
Das Versagen
der Politik




Gefährliches Urteil



Brennpunkt Herz-OP:
Indikation und Infektion




Bakteriophagen
Therapie –
Krankenkasse
muss zahlen!
-mehr-
Therapie –
Krankenkasse
muss zahlen!
-



Das Politmagazin Frontal 21 berichtete
am 17.02.2015 über Krankenhauskeime
am 17.02.2015 über Krankenhauskeime

„Anwalt kämpft gegen Keime“
Das Interview der NNP vom
7.12.2017 finden sie hier.
Das Interview der NNP vom
7.12.2017 finden sie hier.


Gebärmutter-
Umsatzfaktor Frau ?
Umsatzfaktor Frau ?


Facharzt für Infektiologie
Tausende Patienten zu retten
Tausende Patienten zu retten


Streit geht weiter!
Gießener Anzeiger vom 16.03.2020
Gießener Anzeiger vom 16.03.2020